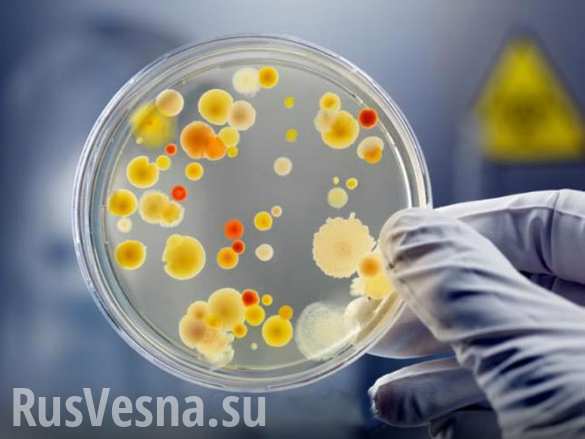
Опасный азарт: сотни посетителей казино в США заразились серьёзной инфекцией Опасный азарт: сотни посетителей казино в США заразились серьёзной инфекцией

Опасный азарт: сотни посетителей казино в США заразились серьёзной инфекцией
Порядка 200 человек заразились норовирусом после посещения казино L’Auberge в американском городе Лейк-Чарльз, штат Луизиана.
Об этом сообщают местные СМИ со ссылкой на директора государственного управления здравоохранения города Лейси Кавано.
«На данный момент не имеет значения, как это началось, потому что сейчас мы наблюдаем передачу вируса внутри общества», — отметила Кавано.
Чиновник напомнила, что норовирус очень заразен. Она пояснила, что люди могут являться переносчиками этого вируса не только тогда, когда у них проявляются симптомы, но также и в течение трёх недель после их исчезновения.
Справка РВ
Норовирус — одних из возбудителей кишечных инфекций, которые проявляются ярко выраженной кишечной симптоматикой: рвота, понос, повышение температуры тела.
Данный тип вируса является очень заразным. Его легко можно подхватить во время употребления пищи, приёма жидкости, через предметы обихода, посуду или немытые руки.